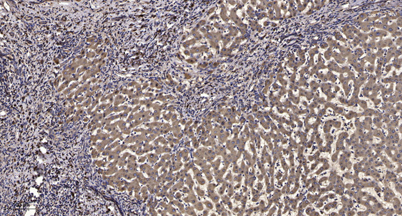

$148.00/50µL $248.00/100µL
| 50 µL | $148.00 |
| 100 µL | $248.00 |
| Product name: | IRF-3 (phospho Ser396) rabbit pAb |
| Reactivity: | Human;Mouse;Rat |
| Alternative Names: | IRF3; Interferon regulatory factor 3; IRF-3 |
| Source: | Rabbit |
| Dilutions: | WB 1:500-2000;IHC-p 1:50-300 |
| Immunogen: | The antiserum was produced against synthesized peptide derived from human IRF-3 around the phosphorylation site of Ser396. AA range:362-411 |
| Storage: | -20°C/1 year |
| Clonality: | Polyclonal |
| Isotype: | IgG |
| Concentration: | 1 mg/ml |
| Observed Band: | 48-55kd |
| GeneID: | 3661 |
| Human Swiss-Prot No: | Q14653 |
| Cellular localization: | Cytoplasm . Nucleus . Mitochondrion . Shuttles between cytoplasmic and nuclear compartments, with export being the prevailing effect (PubMed:10805757). When activated, IRF3 interaction with CREBBP prevents its export to the cytoplasm (PubMed:10805757). Recruited to mitochondria via TOMM70:HSP90AA1 upon Sendai virus infection (PubMed:25609812). . |
| Background: | This gene encodes a member of the interferon regulatory transcription factor (IRF) family. The encoded protein is found in an inactive cytoplasmic form that upon serine/threonine phosphorylation forms a complex with CREBBP. This complex translocates to the nucleus and activates the transcription of interferons alpha and beta, as well as other interferon-induced genes. Alternatively spliced transcript variants encoding multiple isoforms have been observed for this gene. [provided by RefSeq, Nov 2011], |